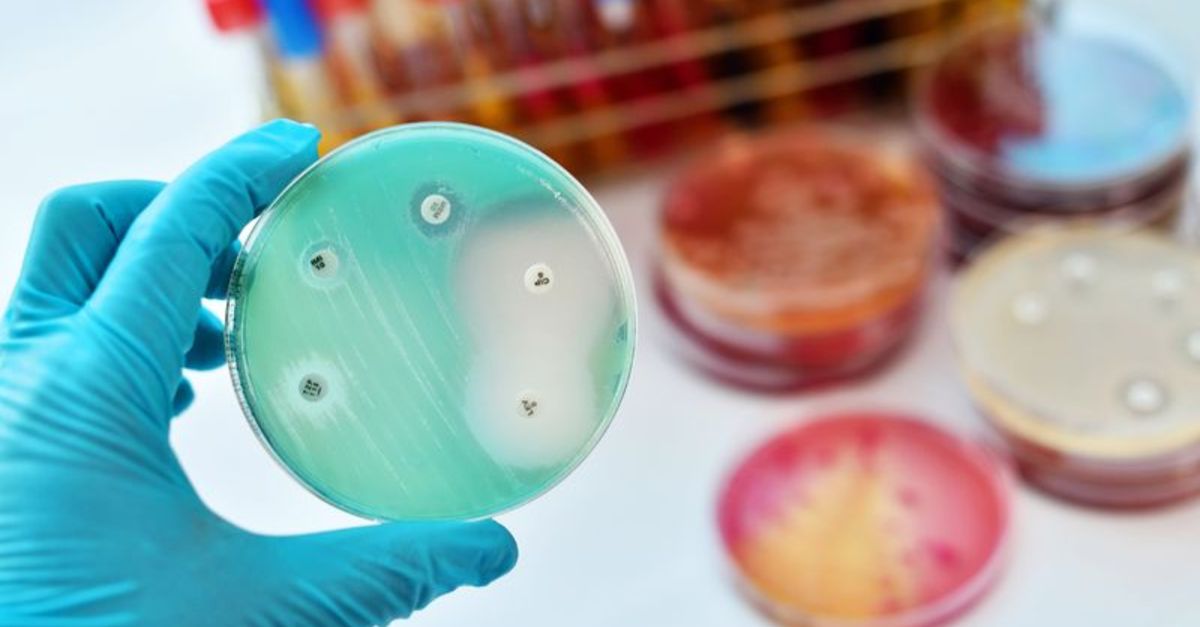

AB Kurulu, ABD merkezli ilaç şirketi Eli Lilly ile Kovid-19 hastalarının tedavisinde kullanılmak üzere monoklonal antikor tedariki için kontrat yapıldığını açıkladı.
Açıklamada, kelam konusu ilacın hali hazırda Avrupa İlaç Ajansı (EMA) tarafından değerlendirilmekte olduğu belirtilerek, AB üyesi 18 ülkenin 220 bin kişinin tedavisine yetecek ölçüde ortak alıma katıldığı kaydedildi.
Kovid-19 ve varyantlarında karşı en tesirli sistemin aşılama olduğuna dikkat çekilen açıklamada, tedavide kullanılacak ilaçların da salgınla gayrette kritik bir rol oynadığı söz edildi.
Açıklamada, ilaçların hayat kurtarmaya, düzgünleşme müddetini hızlandırmaya, hastanede yatışı kısaltmaya ve sıhhat sistemleri üzerindeki yükü hafifletmeye yardımcı olacağına dikkat çekildi.
Eli Lilly ilacının, yüksek riskli koronavirüs hastalarının tedavisinde kullanılmak üzere 2 monoklonal antikor kombinasyonu içerdiği belirtilen açıklamada, monoklonal antikorların bağışıklık sisteminin Kovid-19’la gayret yeteneğini taklit eden proteinler olduğu, virüsün insan hücrelerine bağlanmasını engelledikleri söz edildi.
Açıklamada, ortak tedarik muahedeleri kapsamında AB Kurulu’nun şimdiye kadar farklı tıbbi önlemler için toplam 12 milyar euroyu geçen 200 kontrat yaptığı bildirildi.
AB daha evvel Roche ve Glaxo Smith Kline ile de benzeri ilaç alım mukaveleleri imzalamıştı.
AB Kurulu, ABD merkezli ilaç şirketi Eli Lilly ile Kovid-19 hastalarının tedavisinde kullanılmak üzere monoklonal antikor tedariki için kontrat yapıldığını açıkladı.
Açıklamada, kelam konusu ilacın hali hazırda Avrupa İlaç Ajansı (EMA) tarafından değerlendirilmekte olduğu belirtilerek, AB üyesi 18 ülkenin 220 bin kişinin tedavisine yetecek ölçüde ortak alıma katıldığı kaydedildi.
Kovid-19 ve varyantlarında karşı en tesirli sistemin aşılama olduğuna dikkat çekilen açıklamada, tedavide kullanılacak ilaçların da salgınla gayrette kritik bir rol oynadığı söz edildi.
Açıklamada, ilaçların hayat kurtarmaya, düzgünleşme müddetini hızlandırmaya, hastanede yatışı kısaltmaya ve sıhhat sistemleri üzerindeki yükü hafifletmeye yardımcı olacağına dikkat çekildi.
Eli Lilly ilacının, yüksek riskli koronavirüs hastalarının tedavisinde kullanılmak üzere 2 monoklonal antikor kombinasyonu içerdiği belirtilen açıklamada, monoklonal antikorların bağışıklık sisteminin Kovid-19’la gayret yeteneğini taklit eden proteinler olduğu, virüsün insan hücrelerine bağlanmasını engelledikleri söz edildi.
Açıklamada, ortak tedarik muahedeleri kapsamında AB Kurulu’nun şimdiye kadar farklı tıbbi önlemler için toplam 12 milyar euroyu geçen 200 kontrat yaptığı bildirildi.
AB daha evvel Roche ve Glaxo Smith Kline ile de benzeri ilaç alım mukaveleleri imzalamıştı.










